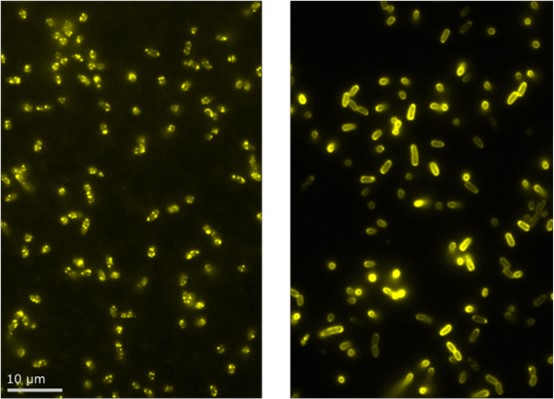
新闻图片12

上海典奥生物科技有限公司
14 年
手机商铺
商家活跃:
产品热度:
- NaN
- 0.8999999999999999
- 1.9
- 0.8999999999999999
- 3.9
Nanoimager单分子成像与功能分析系统
询价
推荐产品
公司新闻/正文
揭秘Nanoimager超分辨率成像背后的利器
904 人阅读发布时间:2021-11-08 16:09
我们在《Nanoimager:20nm超高分辨率技术,将细胞外囊泡行踪尽收眼底》已经了解,Nanoimager单分子成像与分析系统作为新一代超分辨率显微镜的标志性代表,其克服了光的衍射极限,分辨率可达20nm,不仅可以获得超分辨率单分子荧光图像,进行三维成像,同时还可以支持双色成像和顺序四色成像。这些特性使它成为信号通路转导、肿瘤和外泌体标志物、病毒增值和装配、细胞亚显微结构表征等研究领域在单分子水平上进行显微分析的重要帮手。
Nanoimager为何如此强大?其背后又有哪些核心技术支撑?
荧光显微成像是生物学研究的一个重要手段,但由于光学显微镜受到光的衍射限制,分辨率被限制在200nm左右,因此常规光学显微镜无法分辨尺寸在200nm以下的细胞结构。Nanoimager拥有的超分辨率技术dSTORM(随机光学重建显微技术)、PALM(光激活定位显微技术)、smFRET(单分子FRET技术)、Single Particle Tracking(单分子示踪技术)支持了Nanoimager可以在20nm的超分辨率下进行全面的生物学研究。
Nanoimager拥有的dSTORM(随机光学重建显微技术)和PALM(光激活定位显微技术),二者原理相似,是利用光激活方法的新型超分辨率荧光显微技术,成像过程均需要往复循环,在每个循环周期里,荧光分子团被连续的激活、成像及漂白,二者都通过计算(高斯拟合)实现高分辨率单分子定位,精度可以达到20nm,比传统光学显微镜分辨率提高了10倍以上,因此可以帮助用户看到更精细的细胞结构。
dSTORM&PALM优势:
1. 20nm分辨率:XY轴可视化20nm结构
2. 3D成像:Z轴分辨率达到50nm,可3D成像
3.精确定量结果:可计算分子的大小和数量分布,以及空间距离

皮质神经元突触前后结构成像

鼻病毒感染HeLa细胞并破坏高尔基体成像

COS-7细胞核膜和细胞骨架网络成像

FFPE肾组织切片中肾小球足细胞蛋白成像

兔腰肌肌原纤维成像
Nanoimager具有的Single Particle Tracking单分子示踪技术可以在两个通道中同时跟踪纳米级的粒子,并可以计算粒子的大小和数量分布,让荧光标记分子或囊泡的检测变得简单轻松。
Single Particle Tracking优势:
活细胞成像:具有内置的加热控制、自动对焦和微流控设置支持,支持活细胞成像
四个荧光通道,可2个同时成像:可在一个实验中追踪4种不同的分子,同时捕获2种荧光
专有的跟踪分析软件:专有的NimOS软件可实现自动颗粒跟踪以及扩散系数、颗粒大小和浓度的测量

Atlastin1蛋白在成纤维细胞中沿着内质网行走图像

追踪HEK293T细胞内流感病毒HA(HA Dendra)颗粒

内质网线粒体接触位点的动态追踪

成纤维细胞中BHV1行为的研究

可视化活细胞中EVs动力学和相互作用

smFRET(单分子荧光共振能量转移技术)是将2个相互作用的分子标记上颜色不同的荧光基团,一个在能量转移过程中提供能量,即供体D(donor),另一个接受能量,即受体A(acceptor)。然后运用荧光共振能量转移 (FRET) 技术来对体系进行研究,因此比单个荧光基团标记更具有优势。smFRET可以表征各种类型样品的单分子相互作用并进行定量。

Nanoimager是一款为数不多能够进行单分子FRET的商用显微镜。配合专有的NimOS软件,可在2-10nm内实时进行纳米尺操作,一次采集即可追踪数千个FRET荧光事件,不仅可以提高实验结果准确性,也可以加快项目过程。
smFRET优势:
洞悉分子相互作用:确定蛋白质分子的空间位置,识别分子相互作用、结合情况和停顿时间
大视场:可同时捕获数千个单分子,大幅提高实验吞吐量
专有的smFRET分析软件:可绘制和分组个体FRET痕迹及总体平均值

双精氨酸易位(Tat)复合物的组装

此外,Nanoimag专有的NimOS软件在超高分辨率成像中也占据重要作用。NimOS支持用户快速轻松地获取并分析数据,当用户和同事共享显微镜时,也可以不必在同一台计算机上进行采集和分析。
最后,Nanoimager单分子成像与功能分析系统简单易用、设计紧凑,单位面积小于A4纸。它可以始终保持校准状态,样品准备好后可以直接成像,无需花费时间进行调试和校准。使用安全无害的一级激光,可在任何办公室、实验室和教室使用,无需额外配置温控房间、光学平台、激光室或暗室,使用更便捷。
Nanoimager为何如此强大?其背后又有哪些核心技术支撑?
荧光显微成像是生物学研究的一个重要手段,但由于光学显微镜受到光的衍射限制,分辨率被限制在200nm左右,因此常规光学显微镜无法分辨尺寸在200nm以下的细胞结构。Nanoimager拥有的超分辨率技术dSTORM(随机光学重建显微技术)、PALM(光激活定位显微技术)、smFRET(单分子FRET技术)、Single Particle Tracking(单分子示踪技术)支持了Nanoimager可以在20nm的超分辨率下进行全面的生物学研究。
dSTORM & PALM
Nanoimager拥有的dSTORM(随机光学重建显微技术)和PALM(光激活定位显微技术),二者原理相似,是利用光激活方法的新型超分辨率荧光显微技术,成像过程均需要往复循环,在每个循环周期里,荧光分子团被连续的激活、成像及漂白,二者都通过计算(高斯拟合)实现高分辨率单分子定位,精度可以达到20nm,比传统光学显微镜分辨率提高了10倍以上,因此可以帮助用户看到更精细的细胞结构。
dSTORM&PALM优势:
1. 20nm分辨率:XY轴可视化20nm结构
2. 3D成像:Z轴分辨率达到50nm,可3D成像
3.精确定量结果:可计算分子的大小和数量分布,以及空间距离

皮质神经元突触前后结构成像

鼻病毒感染HeLa细胞并破坏高尔基体成像

COS-7细胞核膜和细胞骨架网络成像

FFPE肾组织切片中肾小球足细胞蛋白成像

兔腰肌肌原纤维成像
Single Particle Tracking
Nanoimager具有的Single Particle Tracking单分子示踪技术可以在两个通道中同时跟踪纳米级的粒子,并可以计算粒子的大小和数量分布,让荧光标记分子或囊泡的检测变得简单轻松。
Single Particle Tracking优势:
活细胞成像:具有内置的加热控制、自动对焦和微流控设置支持,支持活细胞成像
四个荧光通道,可2个同时成像:可在一个实验中追踪4种不同的分子,同时捕获2种荧光
专有的跟踪分析软件:专有的NimOS软件可实现自动颗粒跟踪以及扩散系数、颗粒大小和浓度的测量

Atlastin1蛋白在成纤维细胞中沿着内质网行走图像

追踪HEK293T细胞内流感病毒HA(HA Dendra)颗粒

内质网线粒体接触位点的动态追踪

成纤维细胞中BHV1行为的研究

可视化活细胞中EVs动力学和相互作用
smFRET

smFRET(单分子荧光共振能量转移技术)是将2个相互作用的分子标记上颜色不同的荧光基团,一个在能量转移过程中提供能量,即供体D(donor),另一个接受能量,即受体A(acceptor)。然后运用荧光共振能量转移 (FRET) 技术来对体系进行研究,因此比单个荧光基团标记更具有优势。smFRET可以表征各种类型样品的单分子相互作用并进行定量。
Nanoimager是一款为数不多能够进行单分子FRET的商用显微镜。配合专有的NimOS软件,可在2-10nm内实时进行纳米尺操作,一次采集即可追踪数千个FRET荧光事件,不仅可以提高实验结果准确性,也可以加快项目过程。
smFRET优势:
洞悉分子相互作用:确定蛋白质分子的空间位置,识别分子相互作用、结合情况和停顿时间
大视场:可同时捕获数千个单分子,大幅提高实验吞吐量
专有的smFRET分析软件:可绘制和分组个体FRET痕迹及总体平均值

双精氨酸易位(Tat)复合物的组装
NimOS软件

此外,Nanoimag专有的NimOS软件在超高分辨率成像中也占据重要作用。NimOS支持用户快速轻松地获取并分析数据,当用户和同事共享显微镜时,也可以不必在同一台计算机上进行采集和分析。
最后,Nanoimager单分子成像与功能分析系统简单易用、设计紧凑,单位面积小于A4纸。它可以始终保持校准状态,样品准备好后可以直接成像,无需花费时间进行调试和校准。使用安全无害的一级激光,可在任何办公室、实验室和教室使用,无需额外配置温控房间、光学平台、激光室或暗室,使用更便捷。






